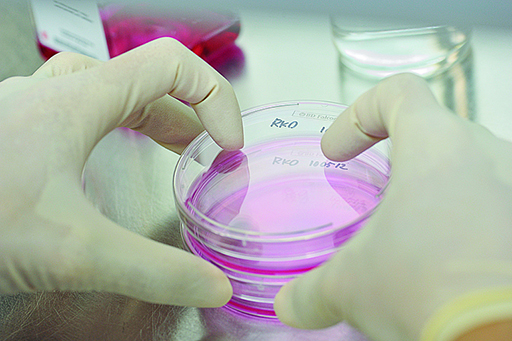

創薬研究は、今も医薬品モダリティの主体は低分子医薬といわれます。しかし、中分子化合物への移行、あるいは抗体医薬品に代表されるバイオ医薬品の成長は著しく、世界のブロックバスターの中心がバイオ医薬品です。
2022年のブロックバスター12位のうちCOVITを対象とするものが3剤。その他低分子化合物は3剤です。最も多かったのはバイオ医薬品の6剤です。
アダリムマブ(ヒュムラ)、ベムプロリズマブ(キイトルーダ)、ウステキヌマブ(ステラーラ)、デュピルマブ(デュピクセント)、セマグルチド(オゼンピック)、ニボルマブ(オブジーボ)がバイオ医薬品です。
一方でバイオ医薬品は、ブラックボックスであり製品の薬価が高額になりやすいというデメリットがあります。しかも投与方法が、注射や点滴に絞られるため、費用や通院時間など患者さんには負担がかかります。
一方で低分子・中分子化合物化のエコでクリーン、再現性が高いという特色は見逃せません。中分子役に挑戦する国内メーカーが登場。核酸医薬品を低分子化合で実現できる状況にもなり、化学が得意な皆さんに朗報といえます。
医薬業界が変化している
病院・薬局・Dgs・企業への就職
病院・薬局・Dgs・企業への就職
